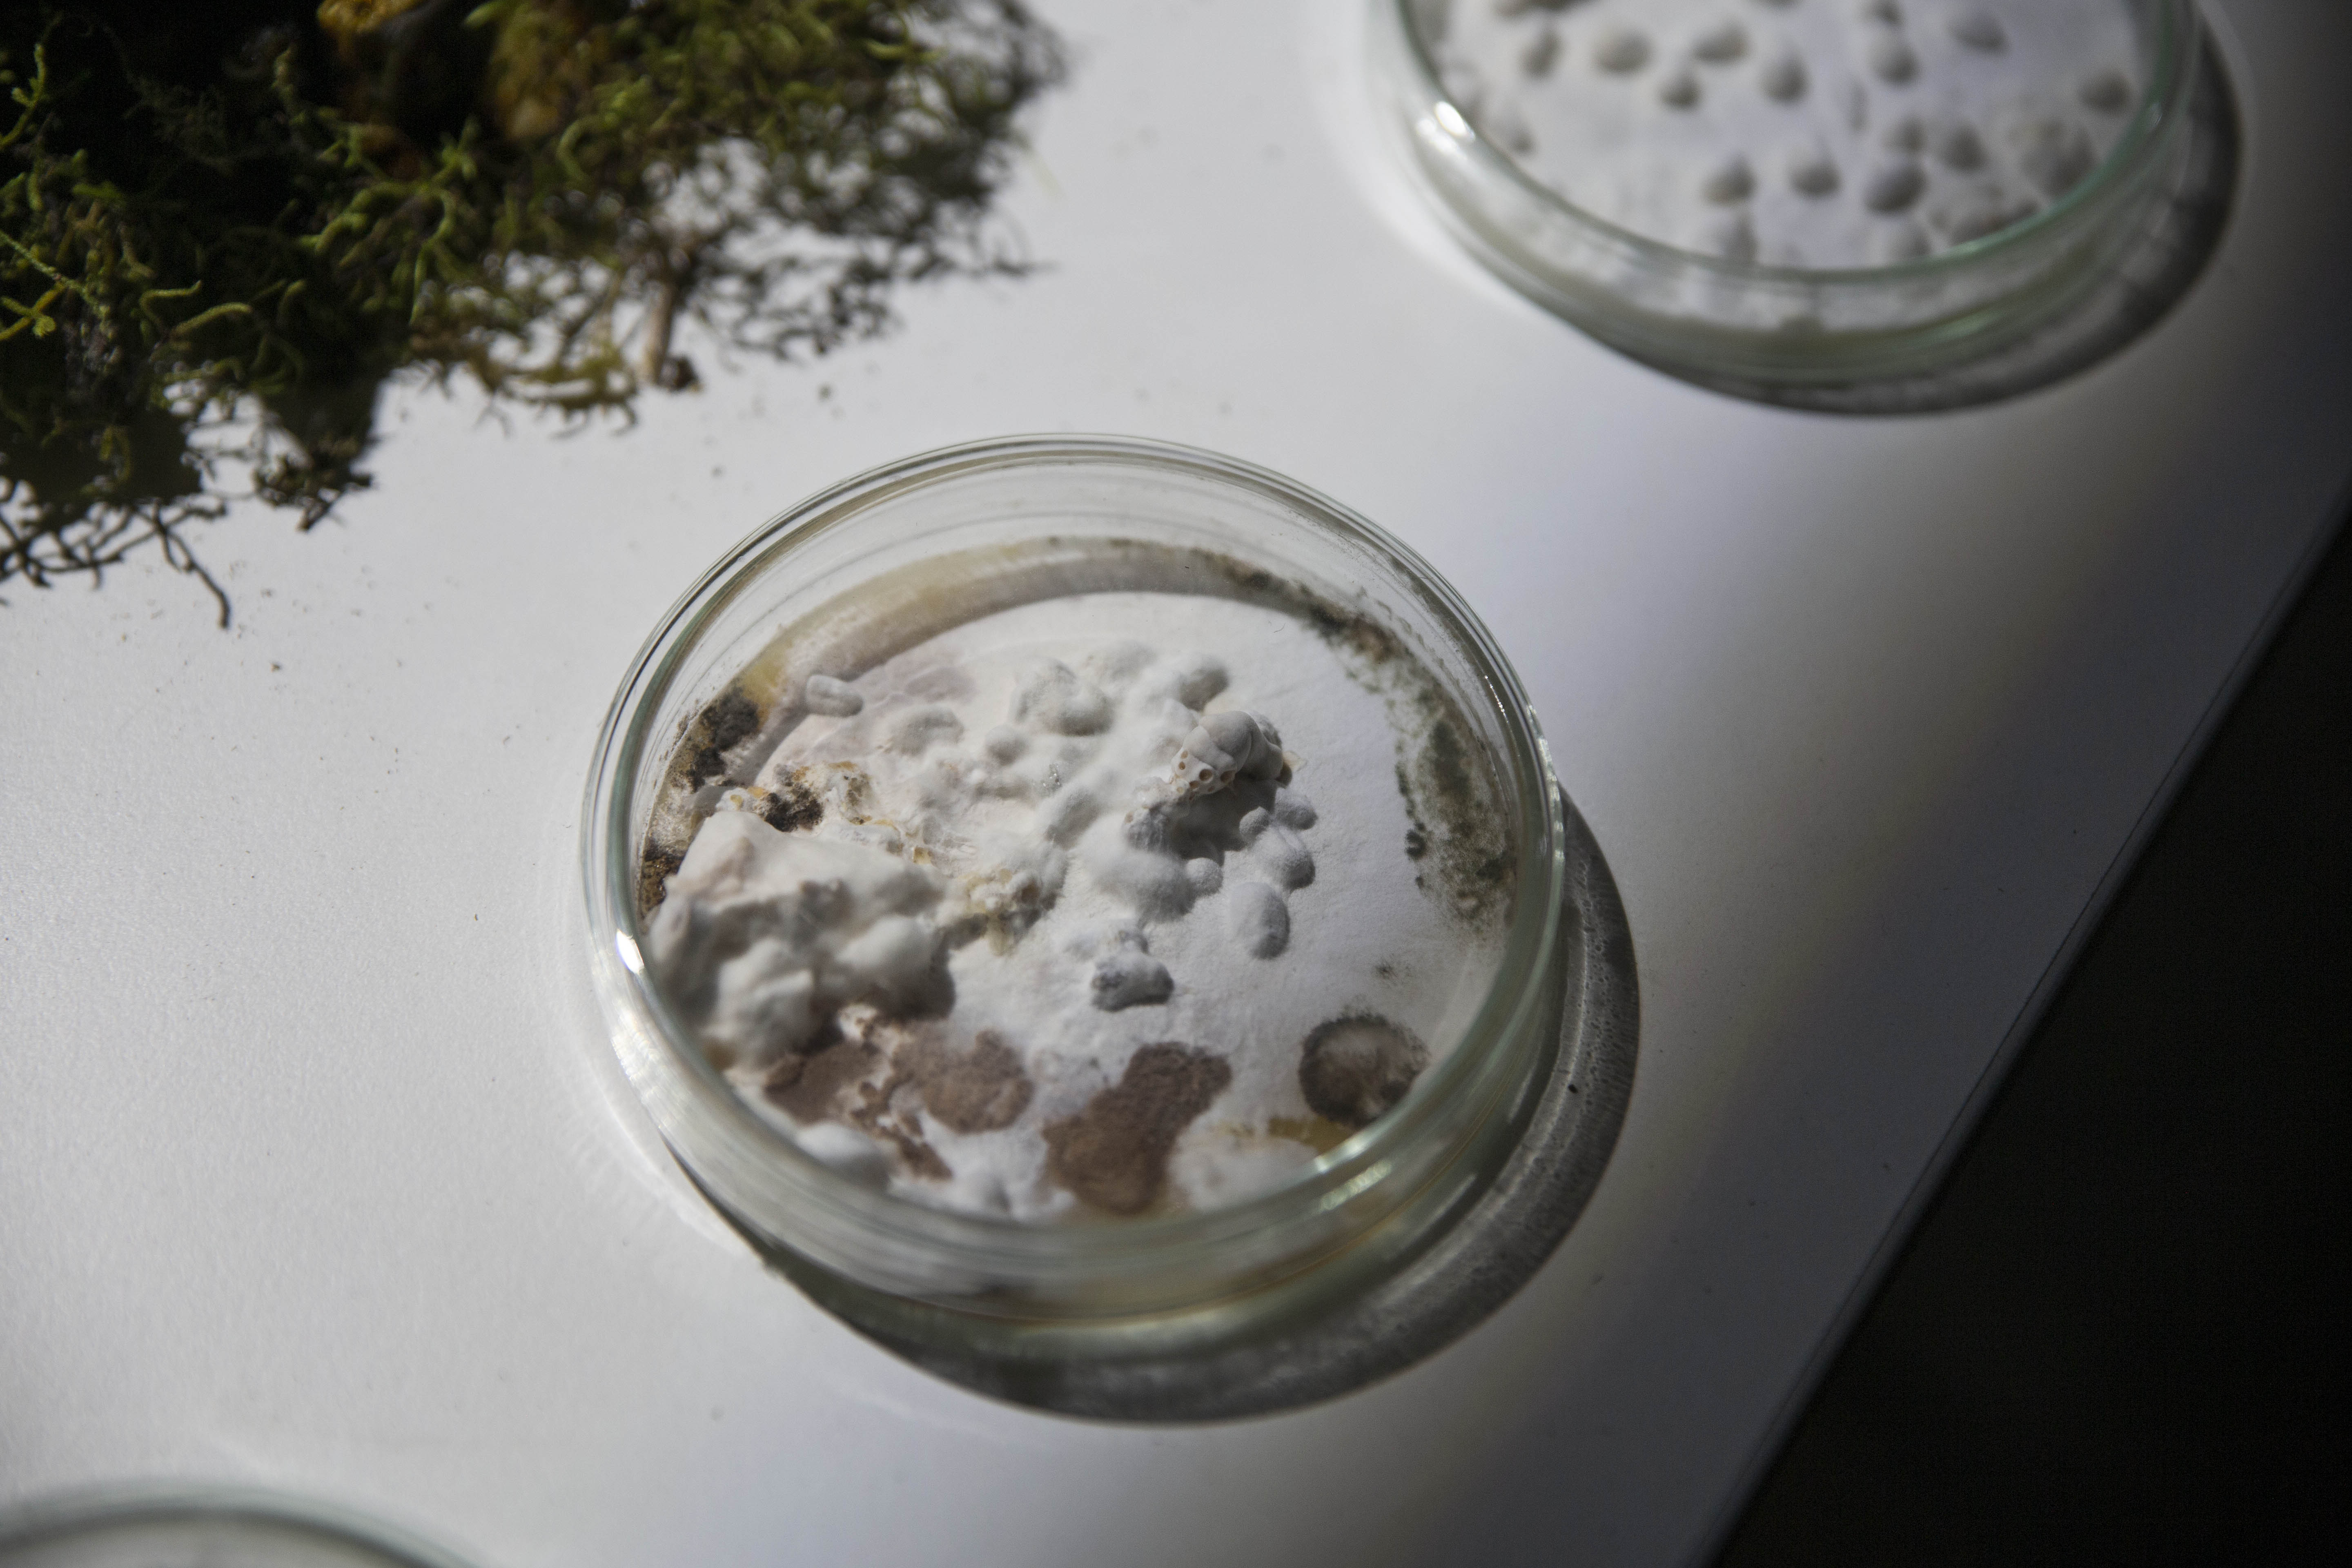

Exposición
Artista: Sofía Córdoba
Curaduría de Fernando López Lage
(…) La instalación cuestiona a través del ensamblaje el modelo esencialista y antropocéntrico. Propone una red indisoluble de individuos, objetos, aparatos y fuerzas naturales, donde lo humano es desplazado y descentrado. La obra alude a entramados de mediaciones parciales, inmanentes y heterogéneas. Las redes poseen ontologías fluidas, precarias y anárquicas; no tienen inicio, causa ni efecto, no están predeterminadas. Abandonan las habituales dicotomías modernas, esencialistas y la falsa idea de pureza, exponiendo las derivas la mutación y lo cyborg. La muestra es una invitación a todas las disciplinas a participar de una plataforma sin convenciones, donde la fluidez y las energías se traducen en un laboratorio de arte y botánica, símbolos y utilidades, realidad y ficción, ciencia y creencia.
Texto completo:
Ontologías fluidas, precarias, anárquicas de F. López Lage
https://drive.google.com/file/d/1pe8o4yGll7GCD0DaDPUkrQrw-GI_A9CO/view?usp=share_link
Nota de prensa de Fernando Barrios para Cooltivarte:
https://cooltivarte.com/portal/entrevista-a-sofia-cordoba-por-su-obra-ficciones-yuxtapuestas/
Nota de Daniel Benoit


